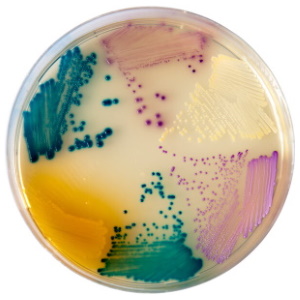
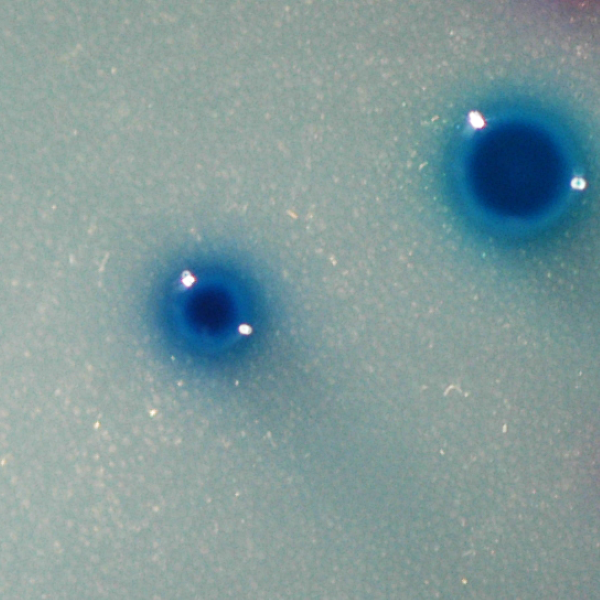
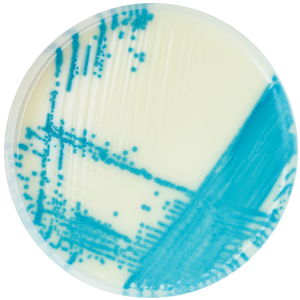

クロモアガー™ 酵素基質培地

基礎培地
グラム陰性菌
クロモアガー™ ESBL
CHROMagar™ ESBL
クロモアガー™ ESBL培地は、基質特異性拡張型β-ラクタマーゼ(ESBL:Extended Spectrum β- Lactamase)産生菌試験用の選択分離培地です。本培地はコロニーの色調により、菌株のスクリーニングも同時に行えます。
クロモアガー™ C3GR
CHROMagar™ C3GR
クロモアガー™ C3GR培地は、第三世代セファロスポリン耐性腸内細菌科細菌試験用の選択分離培地です。本培地はコロニーの色調により、スクリーニングも同時に行えます。
- 【 関連情報 】
 関連製品ページ
関連製品ページ
クロモアガー™ mSuperCARBA
CHROMagar™ mSuperCARBA
クロモアガー™ mSuperCARBA培地は、カルバペネマーゼ産生腸内細菌科細菌(CPE:Carbapenemase Producing Enterobacteriaceae)試験用の選択分離培地です。本培地はコロニーの色調により、菌株のスクリーニングも同時に行えます。
高い選択性を維持しながら、OXA-48のように発現が弱いカルバペネマーゼを含む KPC, NDM, VIM, IMP, OXA等の多種多様なカルバペネマーゼ産生菌をスクリーニングできます
クロモアガー™ COL-APSE
CHROMagar™ COL-APSE
クロモアガー™ COL-APSE培地は、コリスチン耐性菌試験用の選択分離培地です。本培地はコロニーの色調により、菌株のスクリーニングも同時に行えます。
- 【 関連情報 】
グラム陽性菌
クロモアガー™ VRE blue
CHROMagar™ VRE blue
クロモアガー™ VRE blue培地は、バンコマイシン耐性腸球菌(VRE:Vancomycin-resistant Enterococci)試験用の選択分離培地です。
本培地上で VanA および VanB タイプのVRE は青色のコロニーを形成します。
- 【 関連情報 】
 関連製品ページ
関連製品ページ
クロモアガー™ MRSA
CHROMagar™ MRSA
クロモアガー™ MRSA培地は、メチシリン耐性黄色ブドウ球菌(MRSA:Methicillin-resistant Staphylococcus aureus)試験用の選択分離培地です。
本培地上でMRSAは藤色のコロニーを形成します
- 【 関連情報 】
 関連製品ページ
関連製品ページ
微生物検査に関する
お問い合わせ
メールでのお問い合わせ
お電話でのお問い合わせ